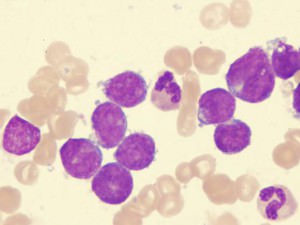

Чтобы развилась лейкемия, достаточно всего одной мутировавшей клетки костного мозга, из которой впоследствии вырастают лейкозные клетки — такие же мутанты. Они растут бесконтрольно, без остановки, вытесняют нормальные лейкоциты, при этом функций лейкоцитов (несмотря на некоторую схожесть строения) не выполняют.
Организм словно сходит с ума, штампуя и штампуя бластные клетки, которые постепенно проникают во все органы и системы, вызывая клиническую симптоматику.
Причины
От чего мутирует та, первая клетка, пока только пытаются понять. Но уже однозначно определены факторы риска, которые приводят к развитию лейкемии. Среди этих факторов генетические, наследственные заболевания, в том числе болезнь Дауна, ферментопатии. К лейкозам может привести лучевое облучение, в том числе на производстве и с лечебной целью при терапии онкологических заболеваний. Курение — один из основных факторов развития специфичной формы лейкоза у мужчин. Повышение концентраций бензола, ароматических углеводородов, метана в месте проживания тоже становятся фоновыми факторами по риску лейкозов.
Симптомы
У каждого типа лейкемии (выделяют пять групп лейкемических процессов, классифицируя их по типу пораженных клеток) особая симптоматика, которая зависит от многих причин. Но общая лейкемическая настороженность должна проявиться в случаях частых простудных заболеваний, которые практически не заканчиваются, следуя друг за другом, переходя из одного в другое.
Слабость, потливость, головокружение, похудание, отсутствие аппетита, изменения пищевых привычек, в том числе отказ от каких-то привычных продуктов тоже должны настораживать. Очень типичной жалобой при лейкемии является указание на легкое возникновение синяков и гематом, кровотечений, увеличение и болезненность лимфатических узлов, боль в суставах и непонятная боль в животе без указания на примерное место локализации.
Диагноз и лечение
Осмотр, данные анамнеза не являются решающими факторами в постановке диагноза лейкемии. Для того, чтобы точно «увидеть» бластный процесс проводят углубленное исследование крови и цитологическое исследование костного мозга. Именно по результатам оценки количественных и качественных показателей ставится диагноз лейкемии и назначается лечение. Лечение лейкемии строится по строго определенным схемам, которые разработаны для каждого типа этой патологии. В лечение могут входить несколько видов терапии, они могут чередоваться, предшествовать друг другу. Применяются комбинации лекарственных препаратов, иммунная терапия, радиологическое лечение, трансплантация клеток костного мозга.
Прогноз
В последние годы прогностические показатели по лейкемии улучшаются. Разработаны новые методы лечения, новые препараты. Лучшие цифры выживаемости — в детском возрасте, до 98%. Во взрослом возрасте прогноз зависит от типа лейкемии, ее стадии, эффективности лечения и возможности осуществить пересадку костного мозга. Цифры пятилетнего прогноза колеблются от 20 до 95%.

